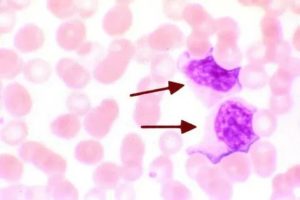
image
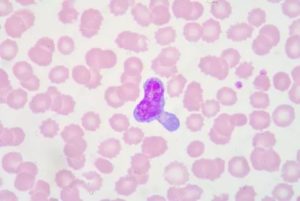
image
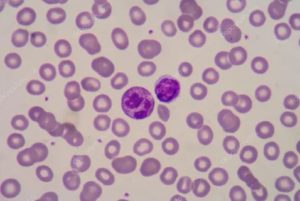
image

Могут ли быть повышены лимфоциты при аллергии

Лимфоциты – белые кровяные клетки, тип незернистых лейкоцитов, которые первыми в иммунной системе регистрируют заболевание. Это своеобразный индикатор состояния организма – они активизируются в момент проникновения в него болезнетворных микроорганизмов. Можно сделать вывод, что лимфоциты повышены у детей, если дети заболели?
Да! С началом воспаления иммунитет снижается, а количество лимфоцитов в крови повышается. За выработку лимфоцитов в организме отвечают белая пульпа селезенки и лимфатические узлы.
Изменение уровня лимфоцитов в крови
Процентное соотношение данных кровяных клеток меняется в зависимости от возраста ребенка. Если лимфоциты повышены у детей младенческого возраста до 61% в общей лейкоцитарной формуле, патологией это не считается. К 12-летнему возрасту 50% зернистых лейкоцитов в анализе крови заставляет родителей беспокоиться о состоянии здоровья подростка.
Но даже если повышен уровень лимфоцитов у ребенка, это не значит, что он неизлечимо болен.
Характер лимфоцитоза бывает двоякий – абсолютное повышение и относительное. Относительное повышение в формуле крови происходит а счет понижения процентного содержания других кровяных клеток. Например, повысились лимфоциты – понизились нейтрофилы.
Относительный лимфоцитоз диагностируется сравнительно недолгое время. С незначительным увеличением защитных клеток в кровяной системе протекает аллергия и обострение бронхиальной астмы, которые для организма опасны, но имеют характер обратимый. Если значительно лимфоциты повышены у ребенка, причины тому могут быть следующие:
- заболевания кишечного тракта;
- профилактические прививки;
- сезонные вирусные инфекции;
- брюшной тиф;
- интонсикация;
- воздействие некоторых лекарственных препаратов.
Падение уровня лимфоцитов может свидетельствовать о пневмонии или болезни самой иммунной системы.
Абсолютный лимфоцитоз наблюдается, если лимфоциты повышены у детей в самом составе крови, а не в ее лейкоцитарной формуле.
Это случается во время острых инфекций, которые могут вызывать серьезные осложнения:
- при паратите;
- при коклюше;
- при цитомегаловирусной инфекции;
- во время острого вирусного гепатита;
- при туберкулезе и други инфекциях.
Онкологические и аутоиммунные заболевания также протекают при абсолютном лимфоцитозе. Организм начинает вырабатывать во время подобных патологических состояний лимфоциты, но созреть они не успевают и в таком виде в избытке насыщают кровеносную систему. Это вызывает кровоизлияние, изъязвление пораженных органов, нарушает их работу. Можно сказать, что организм начинает самоуничтожение.
Нужно ли понижать уровень лимфоцитов в крови
Если лимфоциты повышены у детей по относительному показателю продолжительное время, то нужно обязательно обратиться к врачу.
Каждый случай требует индивидуального подхода. Как понижать уровень белых кровяных клеток и нужно ли этим заниматься, должен решать врач.
В том случае, когда лимфоциты выполняют защитную функцию и способствуют повышению иммунитета, не требуется регулирование их уровня с помощью лекарственной терапии. В подобных случаях нужно помочь крохе восстановить иммунитет с помощью правильного питания и режима дня.
Лечение абсолютного лимфоцитоза зависит от причины, вызвавшей это заболевание. Иногда терапия растягивается на длительное время и становится серьезным испытанием для родителей больных детей и самих малышей.
Лимфоциты: причины повышения и понижения у взрослых и детей
Лимфоциты считают важнейшими элементами иммунной системы: это единственные в организме клетки, различающие «свои» и «чужие» белки.
Лимфоциты способны активировать защитные реакции сразу после контакта с инородным образованием, регулировать силу и продолжительность иммунного ответа.
Повышение либо понижение количества лимфоцитов характеризует состояние иммунной системы на момент времени, когда был взят анализ крови.
Что такое лимфоциты
Лимфоциты по сути – вид лейкоцитов или белых клеток крови. Отличаются очень крупным ядром и однородной цитоплазмой без гранул, за что их отнесли к категории агранулоцитов. Развиваются из клетки-предшественницы в красном костном мозге.
Циркулирует в крови и лимфе около 2% лимфоцитов. Остальные депонируются в лимфоузлах, лимфоидной ткани миндалин и кишечника, в вилочковой железе (тимус) и селезёнке, в костном мозге. Всего на долю лимфоцитов приходится до 39% от всех лейкоцитов.
По функциональному назначению среди лимфоцитов (LYM) выделяют три группы:
- Т-лимфоциты отвечают за клеточный иммунитет, непосредственно контактируя с возбудителями заболеваний;
- В-лимфоциты при контакте с чужеродным белком-антигеном образуют нейтрализующие его антитела (гуморальный иммунитет);
- NK-лимфоциты способны различать «нездоровые» клетки организма, например опухолевые, и разрушать их.
Относительно общего количества лимфоцитов доля Т-LYM 65-80%, В-LYM 8-20% и NK 5-20%.
Норма лимфоцитов может выражаться в абсолютных числах (LYM#), полученных путём подсчёта клеток в 109/л крови, либо в относительных значениях (LYM%) – процентной доле лимфоцитов среди всех лейкоцитов. Норма у взрослых постоянна, 19-39% или 1,0-3,6 х 109/л. Количество лимфоцитов у детей варьируется и зависит от возраста:
- 22-25% от рождения до 4 дня;
- 40-76% до 1 месяца;
- 38-72% до 1 года;
- 26-60% от 1 до 6 лет;
- 24-54% до 12 лет;
- 22-50% в 12-15 лет.
Причины, при которых лимфоциты повышены
Отклонение количества лимфоцитов выше нормальных значений (у взрослых) и выше возрастных норм (у детей) называют лимфоцитозом, относительным или абсолютным.
Относительный лимфоцитоз (LYM%) наблюдается при снижении количества лейкоцитов-нейтрофилов (нейтропения), встречается при базедовой и аддисоновой болезнях, хроническом увеличении селезёнки, при голодании и неполноценном питании, после острых инфекций и прививок.
Увеличение LYM% одновременно с LYM# — при туберкулёзе, сифилисе, коклюше и после подкожного введения адреналина. При редкой форме язвенной ангины лимфоцитоз сочетается с появлением юных форм клеток – лимфобластов. При лимфатических лейкемиях абсолютный лимфоцитоз может достигать 0,3-0,5 миллионов в кубическом мм крови, а относительный составлять 90-95%.
Возможно развитие лимфоцитоза в виде реакции на внешнюю угрозу, либо появление его в связи со злокачественными изменениями в клетках самого организма.
Реактивный лимфоцитоз характерен для инфекционных и вирусных заболеваний, в случае аллергических реакций наблюдают лимфоцитоз в совокупности с повышением количества эозинофилов.
Показатели LYM нормализуются через 1-3 месяца после выздоровления или прекращения контакта с аллергеном.
В динамике анализов наблюдается пик и падение количества лимфоцитов; в период выздоровления – снова подъём LYM, т.н. постинфекционный лимфоцитоз.
Злокачественный лимфоцитоз – проявление онко-заболевания, острого или хронического лейкоза. Количество LYM постоянно растёт, некоторое снижение показателей может подтверждать эффективность лечения. Возврат к норме происходит только в случае полного выздоровления, через полгода и даже год после болезни.
Причины лимфоцитоза
- инфекционный мононуклеоз (вирус Эпштейна-Барра);
- адено- и герпес-вирусы;
- ВИЧ;
- вирус Т-клеточной лейкемии (человека);
- инфекционный лимфоцитоз – Коксаки, полио- и энтеровирусы;
- коклюш, ветрянка, скарлатина, краснуха, вирусный паротит (свинка), корь;
- гепатиты В, С.
Бактериальные инфекции
- туберкулёз;
- брюшной тиф;
- бруцеллёз.
Заражение простейшими (токсоплазмоз) и гельминтами.Аллергические реакции на пищу, лекарства, прививки.Лимфоцитарные стрессы после удаления селезёнки, при курении, травмах.Аутоиммунные болезни (ревматоидный артрит).Гормональные нарушения с гиперфункцией щитовидной железы.Лимфоидные опухоли – лейкозы.Физиологические причины:
- у детей лимфоцитоз можно обнаружить после дня на пляже, но показатели возвращаются к норме через 3-5 дней;
- у женщин во время и 2-3 дня после менструации повышено количество LYM.
Лечение лимфоцитоза
Повышение LYM – только отдельный признак, он лишь свидетель заболевания. Чтобы вылечить лимфоцитоз, нужно найти его причину и воздействовать именно на неё.
- витамины А,С,Е – как антиоксиданты, защищающие клетки от повреждений;
- полноценное белковое питание – белки нужны для образования антител;
- обильное тёплое питьё, чтобы снизить интоксикацию и не допустить обезвоживания;
- противовоспалительные средства – только после еды, иначе будут проблемы с желудком;
- иммуноглобулины человека – в тяжёлых случаях, чтобы организм получил готовые антитела.
Причины, при которых лимфоциты понижены
Термином «лимфопения» обозначают количество лимфоцитов, пониженное относительно нижней границы нормы у взрослых и возрастной нормы — у детей.
Чаще встречается относительная лимфопения (снижение процентной доли лимфоцитов) – при сепсисе, крупозном воспалении лёгких, лейкемическом миелозе. Абсолютная лимфопения наблюдается реже, при остро протекающих инфекционных заболеваниях и в случае обширного распада лимфоидной ткани (туберкулёз лимфоузлов, саркома).
Лимфопения всегда указывает на состояние иммунодефицита, врождённое или приобретённое.
- аплазия (недоразвитие либо отсутствие) стволовых клеток, отвечающих за синтез лимфоцитов;
- снижение количества Т-лимфоцитов, лимфопения по типу Т-СD4+;
- синдром Вискотта-Олдрича (триада признаков — экзема, иммунодефицит, снижение количества тромбоцтов);
- опухоль вилочковой железы – тимома.
Приобретённые причины лимфопении:
- инфекционные заболевания (сепсис, грипп, туберкулёз, гепатиты, ВИЧ, пневмония);
- инфаркт миокарда;
- проблемы питания (недостаток белка, дефицит цинка);
- вредные привычки (алкоголизм, курение);
- после лечения (химиотерапия, радиация, цитостатики и глюкокортикоиды);
- при системных заболеваниях с аллергическими реакциями на собственные ткани (болезнь Ходжкина, апластическая анемия, ожоговая болезнь, системная красная волчанка, энтеропатии с потерей белка).
Лечение лимфопении
Сочетает специфическое лечение основных заболеваний, ставших причиной снижения количества LYM, и воздействие на общие проявления болезней.
Часто при лимфопении наблюдаются:
- проблемы с кожей – экзема, гнойные воспаления;
- выпадение волос (алопеция);
- язвы в ротовой полости;
- увеличение селезёнки, лимфоузлов;
- уменьшение миндалин;
- рецидив (возврат) инфекционных заболеваний, ранее протекавших с лимфоцитозом (ветрянка, краснуха, корь и т.д.).
- Лимфоцитоз и лимфопения – повод пройти дополнительное обследование (рентген, УЗИ, томография).
- Оценка уровня лимфоцитов у детей проводится по возрастным нормам.
- Увеличение либо уменьшение количества лимфоцитов – признак проблем с иммунной системой, но не диагноз.
- Лечение проводят только профильные специалисты. Приверженность домашним методам в лучшем случае обернётся лишь потерей времени.
Герпес 6 типа. Повышенные лимфоциты. Пищевая аллергия
Добрый день, Евгений Олегович. Моей дочке 2,5 года. С рождения повышены лимфоциты (от 74 до 86% при норме до 49). Родилась на 34 неделе, преждевременные роды, кратковременное апноэ, кровоизлияние в мозг. 2 недели дочь была в реанимации и палате интенсивной терапии, кормили смесью, с третьей недели кормила грудью.
После введения прикорма постоянные кожные высыпания на пищу (красноватые шелушащиеся пятна на руках, ногах, попе). А до введения прикорма высыпания были на лекарства (почти регулярный прием лекарств на первом году, связанных с перенесенным кровоизлиянием в мозг. По неврологии сейчас все хорошо, развивается нормально.). До сих пор не может есть все, что связано с пшеницей, в т.ч.
пшеничную кашу, с молоком коровьим, в т.ч сыры, творожки (козье не пробовали), с кукурузой, мясом (кроме кролика). После этих продуктов краснеют щеки и на следующий день появляются пятна на ручках и тд. В 1,5 года сдавали анализ кала на дисбактериоз, нашли Klebsiellu и лактазную недостаточность. Пролечили фуразолидоном, Секстафагом, лактазаром. Стало немного лучше.
Стали есть потихоньку разные продукты. Сейчас опять высыпания, снова на диете. Лимфоциты сохраняются на высоком уровне. Иммунолог назначила анализы на вирусы. Нашли вирус Герпеса 6 типа. Антитела 2,322 при норме до 1,923.Сдали анализ на Герпес 6 типа из зева и ДНК крови. Зев – положительно, Кровь 1.0*101 копий HHV6/105 клеток (аналитическая чувствительность 5 копий ДНК HHV6/105 клеток).
Иммунолог назначила ацикловир (либо Зовиракс 0,2, но покупать сказала лучше за границей, т.к. у на 50% подделки), кушать всё и параллельно принимать Натрия Кромогликат (заказывать на сайтах в Интернете, т.к. в аптеке не продается) и ГенферонЛайт свечи. Иммунолог связывает пищевые высыпания на коже именно с Герпесом 6 типа.
Сдали также, по назначению иммунолога, пищевой паспорт на аллергены. Он показал все наоборот: те продукты, которые дочь ест без последствий, показывает, что есть реакция +++ и ++++, а те, на которые высыпает – нет реакции или +. Иммунолог говорит, что на фоне Герпеса 6 типа пробы оказались ложными.
Педиатр-гастроэнтеролог говорит, что герпес 6 типа никак не влияет на наши пищевые проблемы, это все лактазная недостаточность (она сейчас сохраняется, последний анализ сдали месяц назад, Klebsiellа нет, лактаза 0,2-0,4% при норме 0), а Герпес может повлиять на то, что ребенок будет часто болеть, когда пойдет в детсад.Со своей стороны назначила Лактозар, фуразолидон, энтеросгель, диету.
От прививок медотвод. Еще никаких не делали. И с лимфоцитами какая-то неразбериха. Всегда были повышены. А месяц назад сдали – 35, при норме до 37. Пересдали в другой лаборатории через неделю – 86, при норме до 49. Сдали еще через неделю в самом вроде бы точном центре ОКДЦ в Ростове, показывают 58 при норме 38-72).
Иммунолог говорит, что когда герпес активируется, лимфоциты повышаются, а потом снижаются. Так ли это? Нужно ли лечить Герпес 6 типа? Связан ли он с высыпаниями на пищу? Или все-таки его не трогать, а вылечить лактазную недостаточность? Как все-таки определить уровень лимфоцитов, может, они в норме, и не надо трогать ни лимфоциты, ни герпес?
Источник: https://allergen-net.ru/mogut-li-byt-povysheny-limfocity-pri-allergii.html
Атипичные лимфоциты: норма и причины появления атипичныех лимфоцитов в анализе крови
Не секрет, что за борьбу с болезнями в нашем организме отвечают крохотные тельца, называемые антителами. За их выработку отвечает красный костный мозг — орган кроветворения, в недрах которого созревают новенькие иммунные клетки: лимфоциты, нейтрофилы, базофилы, эозинофилы и моноциты.
Главнейшим агентом иммунного ответа являются лимфоциты — их численность в крови преобладает над всеми остальными, именно с помощью них организм ведёт основную борьбу с инфекцией. Большинство лимфоцитов имеет правильную круглую форму и чёткие контуры, однако есть клетки, параметры которых немного отличаются от «оригинала». Такие клетки учёные называют атипичными.
Атипичные или реактивные лимфоциты — это особые иммунные тела, появляющиеся при аллергических реакциях, инфекционных и других заболеваниях. Неправильная форма и размер клеток обусловлены воздействием патогенных микроорганизмов, полностью меняющих их структуру. В норме атипичные иммунные тела не должны появляться вообще, а их наличие может указывать на развитие различных заболеваний.
В этой статье мы расскажем вам, что делать, если в вашем анализе крови обнаружены атипичные лимфоциты, поведаем о причинах, которые могли спровоцировать их рост.
В чём проявляется атипичность лимфоцитов?
Как известно, лимфоциты участвуют в процессах иммунного ответа — то есть, одни из первых бросаются на борьбу с опасными микроорганизмами. В результате этой борьбы они могут приобретать следующие параметры:
- Нестандартный внешний вид
Обычно лимфоцит имеет круглую форму и ровные границы. Атипичные лимфоциты отличаются рваными контурами и неправильной многоугольной структурой.
В нормальном состоянии размер лимфоцита не превышает 12 мкм. Увеличение этого показателя говорит о его атипичности.
Воздействие патогенных организмов распространяется также и на ядро клетки — если посмотреть на неправильный агранулоцит через микроскоп, можно обнаружить, что оно вытянуто, удлинено, испещрено продолговатыми трещинками.
Атипичные лимфоциты также имеют более яркий окрас, при добавлении в анализируемую кровь красителя гематоксилина — это также один из способов выявления необычных клеток.
А вы знали, что черты характера человека влияют на его уровень сопротивляемости болезням? Есть исследование, подтверждающее, что активные и уверенные в себе люди вырабатывают большее количество клеток иммунного ответа, что и помогает им бороться с болезнями. Таким образом, оптимистичный и положительно настроенный человек имеет меньше поводов для беспокойства о своём здоровье.
Причины появления атипичных лимфоцитов
Многие люди, напуганные различными статьями в интернете и медицинских справочниках, уже на рефлекторном уровне начинают паниковать при виде слов «атипичный», «неправильный» и «мутагенный», ассоциируя их с онкологическими заболеваниями. Не спорю, повышенное число лимфоцитов, как и появление атипичных лимфоцитов, может являться косвенным симптомом рака, но это лишь одна из возможных причин, причём не самая распространённая.
Гораздо чаще к усилению выработки лимфоцитов приводит какая-либо инфекция или же аллергическая реакция. Такое явление называют лимфоцитозом. Медики различают три разновидности данного заболевания: реактивный, постинфекционный и злокачественный. Первые два связаны с ослаблением функций организма в результате инфекции, третий — с наличием опухолевого процесса в организме.
Лимфоцитоз неизбежно ведёт к образованию неправильных лимфоцитов, а точнее, он является одним из факторов, сопутствующих данной патологии. Причин у неё может быть несколько:
- Приём определённого круга лекарственных препаратов (к примеру, иммунных сывороток органического происхождения);
- Инфекционные заболевания: пневмония, ветрянка, гепатит и т.д.
- Бруцеллёз — заболевание, поражающее домашних животных. Попадая в организм человека через продукты питания, может вызывать нарушение в работе различных систем, в том числе и иммунной;
- Токсоплазмоз — заболевание без явной клинической картины, поражающее, однако, иммунные клетки организма и приводящее к возникновению реактивных лимфоцитов;
- Лимфолейкоз — злокачественное поражение лимфатических узлов, характеризующееся накоплением в них раковых клеток;
- Коклюш — заболевание дыхательных путей, сопровождаемое судорожным кашлем. Чаще всего встречается у детей;
- Сывороточная болезнь — аллергия на препараты животного происхождения;
- Сифилис на некоторых стадиях.
Уровень агранулоцитов в крови определяется общим анализом крови (на тромбоциты, эритроциты и лейкоциты). Сдаётся такой анализ обычно с утра и на голодный желудок.
Стоит отметить, что в крови взрослого человека можно обнаружить атипичные лимфоциты и при отсутствии патологического процесса в организме, поэтому так важно проконсультироваться с врачом насчёт результатов вашего анализа — именно он первым заметит неладное и посоветует, что делать в сложившейся ситуации.
Ещё одним немаловажным фактором развития атипичных агранулоцитов является аллергия. Врачи по всему миру твердят о том, что аллергические реакции станут одной из главных проблем, преследующих городских жителей в XXI веке.
Дело в том, что в условиях экологических катаклизмов и загрязнённости воздуха, иммунная система человека начинает работать неправильно, «сбоить».
Официальная статистика показывает, что уже сейчас число болеющих аллергией детей составляет 15%!
Норма атипичных лимфоцитов и лечение
В организме здорового человека может содержаться до 6 % атипичных лимфоцитов, большая часть из них консолидируется в кровеносной системе. Стоит встревожиться, если этот уровень превышает 7-10%, именно на это и необходимо указать своему врачу.
Лечение атипичных лимфоцитов, естественно, заключается в выявлении первопричины, а до тех пор не стоит прибегать к каким-то серьёзным мерам.
Чаще всего врачи назначают:
- Витаминно-минеральную терапию, укрепляющую иммунитет.
- Если заболевание имеет вирусную природу, соответственно назначаются антибиотики и противовирусные препараты.
- Антигистаминные и противоаллергические лекарства, если образование атипичных лимфоцитов спровоцировано аллергией.
Не стоит забывать также и о правильном питании, здоровом образе жизни и других мероприятиях, направленных на укрепление организма.
Резюмируя:
Лимфоциты — это группа иммунных клеток крови, подвид лейкоцитов, участвующая в борьбе организма с инородными телами и вирусами.
Когда иммунная клетка сталкивается с серьёзной проблемой, его структура, размер и цвет могут меняться, и тогда можно говорить о развитии его атипичности.
Норма атипичных лимфоцитов в крови человека составляет 6%, всё, что выше — свидетельствует о негативных изменениях в работе организма. Эти нарушения, в свою очередь, могут быть вызваны как вирусами, так и опухолевыми процессами, требующими немедленного лечения.
На этом всё, следите за состоянием своего организма, ведите здоровый образ жизни и не пускайте на самотёк имеющиеся проблемы, именно в этом и заключается секрет крепкого здоровья. Удачи!
Источник: https://sdamanaliz.ru/analiz-krovi/atipichnye-limfotsity.html
Лимфоциты повышены из-за аллергии — АллергииНет
Реактивные лимфоциты способны повышаться при наличии серьезных патологий. Большинство людей уверены, что их повышение связано с тем, что в организме разрастается опухоль, однако это неверно. Такие тельца указывают на аллергию или развитие инфекционного заболевания.
Лимфоциты – подвид лейкоцитов, функцией которых является защита организма от чужеродных агентов. Они помогают уничтожить бактерии и патогенные вещества.
Под воздействием болезнетворных факторов клетки крови увеличиваются в количестве и начинают борьбу с патологией.
Если у ребенка в анализе повышены атипичные лимфоциты, то такие показатели опасны и требуют срочного медицинского вмешательства.
Реактивные лимфоциты: почему появляются?
Борцами с инфекциями и заболеваниями в организме считаются маленькие красные тельца антитела. Антитела вырабатываются в костном мозге, а вместе с этим созревают и новые клетки:
- нейтрофилы,
- эозинофилы,
- базофилы,
- моноциты,
- лимфоциты.
Главными составляющими иммунитета являются лимфоциты, благодаря им происходит подавление чужеродных тел и бактерий.
В основном лимфоциты четкой округлой формы, но могут появляться клетки, которые одинаковые по функциональности, но разные по форме, классифицируют их реактивными либо атипичными.
Атипичные, или реактивные, лимфоциты – антитела, которые появляются в результате аллергической реакции или инфекционного заболевания.
Измененная форма кровяных телец связана с тем, что микроорганизмы размножаются и нарушают нормальное функционирование организма.
Такие клетки не должны появляться при стабильной работе внутренних систем человека, так как их наличие означает поражение организма бактериями, которые размножаются и провоцируют прогресс заболеваний.
В чем атипичность кровяных телец?
Лимфоциты одни из главных борцов с бактериями и микроорганизмами, участвуют в процессах реакции иммунитета на чужеродные тела. Когда лимфоциты повышены в ходе борьбы с чужеродными телами, то соответствуют определенной характеристике.
- Измененный внешний вид и форма.
Стандартные лимфоцитарные клетки имеют ровную круглую форму, а атипичные отличаются рваными контурами и кривой многоугольной формой.
- Увеличение размеров. Размер нормальных телец не превышает 12 мкм. Если показатели и размеры клеток увеличиваются у детей, это означает, что аллергическая реакция и заболевание прогрессируют интенсивно.
- Видоизменение ядра. Если посмотреть через микроскоп на увеличенную модель кровяных телец, то можно заметить, что они имеют видоизмененную форму, их объем больше. Ядро увеличивается в ширину и длину, образовываются странные пятна и трещинки, которые указывают на то, что чужеродные тела распространяются дальше.
- Окрас и изменение цвета.
Реактивные тельца имеют яркий красный цвет, именно по такому признаку их отличают в увеличенном виде. Чтобы определить наличие таких антител, можно добавить гематоксилин, который поможет понять, реактивные лимфоциты или нет, есть ли инфекционные заболевания.
Специалисты выяснили, что от психического состояния человека и его настроения зависит увеличение реактивных лимфоцитов, то есть в состоянии стресса или депрессии показатели увеличиваются вдвое.
Медики утверждают, что хорошее настроение значительно влияет на увеличение лимфоцитов и их более активную борьбу с микроорганизмами.
Почему появляются реактивные лимфоциты?
Если у ребенка увеличиваются лимфоциты, то родители беспокоятся и накручивают себя. Многие считают, что это явный признак развития онкологического процесса. 90% родителей думают, что слово «атипичный» синоним слова «неправильный», однако это не так.
https://www..com/watch?v=23S96rk_gt0
Повышение атипичных лимфоцитов признак заболеваний, однако это не означает, что прогрессирует опухоль и разрастаются раковые клетки.
В основном лимфоциты увеличиваются в результате попадания инфекции или аллергии, такое явление специалисты именуют лимфоцитозом.
Врачи разделяют красные тельца крови на разновидности:
- реактивные,
- постинфекционные,
- злокачественные.
Повышение реактивного и постинфекционного уровня телец не столь опасно, так как этот признак указывает на развитие инфекционных заболеваний в организме и на увеличение численности патогенных клеток в крови. Злокачественные лимфоциты появляются, когда заболевание не перестает прогрессировать, или в организме развивается раковая опухоль.
Причин повышения реактивных лимфоцитов у ребенка и взрослых много, однако основными считаются:
- инфекционные заболевания, которые прогрессируют и нарушают нормальное состояние организма (ветряная оспа, пневмония, гепатит, паротит),
- прием антибиотиков и медицинских средств, которые вызвали аллергическую реакцию (витамины, антибиотики для повышения иммунитета),
- бруцеллез, который при попадании в человеческий организм нарушает нормальную работу и состояние здоровья человека,
- токсоплазмоз, который нарушает иммунную систему и ее борьбу с микроорганизмами и бактериями,
- лимфолейкоз или онкология лимфатических узлов (связано с тем, что раковые клетки накапливаются в лимфоузлах и провоцируют появление реактивных лимфоцитов),
- коклюш – заболевание, которое поражает дыхательную систему (появляется у ребенка в любом возрасте и провоцирует появление атипичных лимфоцитов в крови),
- инфекционное венерическое заболевание сифилис, который прогрессирует и стимулирует процесс появления реактивных лимфоцитов.
Уровень лимфоцитов в крови определяется при сдаче общих анализов крови, то есть сдавать можно всем, в том числе и детям. Анализ сдается утром на голодный желудок, ведь так уровень болезнетворных клеток определить можно гораздо быстрее.
Если в крови у ребенка или взрослого уровень атипичных лимфоцитов повышен без причины, то лучше обратиться к лечащему врачу и получить подробную консультацию о том, каким должно быть лечение.
Норма лимфоцитов и методы лечения
В крови человека содержится приблизительно 6% лимфоцитов, они проходят по кровеносной системе и вырабатываются в костном мозге.
Повышенные показатели в 7-10% являются патологическими и опасными, в таком случае необходимо обратиться к лечащему врачу и выяснить, с чем связаны симптомы.
В основном назначают такие методы лечения:
- специальную витаминно-минеральную терапию, которая эффективна, безопасна и поможет укрепить иммунную систему,
- если аллергическая реакция беспокоит часто и является хронической, то назначают специальные антибиотики и препараты, которые помогут иммунной системе бороться с микроорганизмами и чужеродными телами,
- назначают специальные препараты или исключают те, на которые в организме бурная реакция, в результате чего повышаются лимфоциты.
Стоит учесть, что у каждого организм индивидуальный, показатели могут быть разными, и в случае их увеличения необходимо обратиться к лечащему врачу. Патологические изменения в составе крови говорят не только, что в организме есть вирусные заболевания, но и что иммунная система бурно реагирует на микроорганизмы. Это можно точно определить с помощью общего анализа крови.
https://www.youtube.com/watch?v=VezX5E5raww
Подробней о реактивных изменениях в крови можно узнать из видеоролика:
Источник: https://alerginet.ru/limfoczity-povysheny-iz-za-allergii.html
Атипичные лимфоциты: норма в анализе крови у взрослых и детей, причины повышения

Противостоять болезням организму помогают антитела. Их выработка происходит в костном мозге. Здесь идёт созревание лимфоцитов, нейтрофилов, базофилов, эозинофилов, моноцитов. Больше всего образуется лимфоцитов – главных борцов иммунной системы, которые занимаются защитой организма.
Наряду с ними существуют клетки с особыми параметрами, функциями. Атипичные лимфоциты – это разновидность иммунных тел. Причиной их появления становятся аллергические реакции, инфекции. Воздействие патогенных организмов меняет их структуру, форму. При нормальном состоянии человека они отсутствуют.
Разного рода заболевания провоцируют их появление.
Особенности
Атипичный или реактивный лимфоцит имеет особенности. Его отличают:
- Форма неправильного многоугольника с рваными краями. Для здорового лейкоцита характерны ровные границы, округлость.
- Увеличение размера. Самыми крупными лейкоцитами являются макрофаги. Их размер достигает 12 мкм. Для лимфоцитов характерен небольшой размер. Они увеличиваются под влиянием вирусов и достигают 30 мкм.
- Клеточное ядро вытягивается, становится продолговатым. При исследовании под микроскопом видны трещины.
- Окрашивание в яркий цвет при анализе с использованием гематоксилина и эозина. Клетки меняют окрас на синий, иногда на тёмно-серый. Цвет ядра становится фиолетовым.
Чтобы выявить присутствие аномальных клеток, анализируют состав крови, так как она содержит большое число иммунных тел. Ткани организма аккумулируют их в меньшем количестве.
Разновидности
Структура клетки меняется под воздействием микроорганизмов. Как результат, полностью меняются её функции и параметры.
Дегенеративные
Период длительной интоксикации приводит к образованию дегенеративных клеток, которые не способны делиться и функционировать из-за скопившихся токсинов. Их размер уменьшается либо увеличивается. Виновниками изменений называют дистрофию печени, сепсис, абсцесс.
Клетки Дауни
Размер атипичных мононуклеаров больше, чем здоровых лимфоцитов. Для них характерно наличие моноцитарного ядра. Лимфомоноциты являются показателем наличия вирусной инфекции. Чаще всего это герпес либо мононуклеоз. Выздоровление приводит к нормализации состава крови.
В крови у детей атипичные мононуклеары присутствуют в количестве не более 1%. Показатели могут быть повышены из-за недавно перенесённых болезней или прививки. У взрослых их также обнаруживают.
Появление таких клеток связывают с ростом вероятности заражения герпесом или проявлением аллергии.
Клетки-тени Боткина-Клейна-Гумпрехта
Это понятие включает разрушенные лимфоидные клетки, полученные при подготовке исследуемого материала к анализу. Это значит, что кровяные тельца подвержены быстрому разрушению. Из-за сложности обнаружения они названы тенями. Характерно для хронического лимфолейкоза.
Клетки Ридера
Обнаружение почкообразных клеток с ядрами, имеющими зазубренный контур, сигнализирует о серьёзных заболеваниях. Чаще всего человек болен лейкемией, пернициозной анемией, тяжёлыми инфекциями.
Что вызывает появление
При обследовании обнаруживают атипичные лимфоциты в анализе крови даже при отсутствии жалоб.
При развитии болезни их число растёт, попутно появляются новые атипичные клетки, главными виновниками возникновения которых становятся инфекции вирусного происхождения, аллергия. Попадание микробов внутрь организма провоцирует защитную реакцию иммунной системы.
Начинается выработка антител для борьбы с возбудителем заболевания. При сниженной иммунной защите созревание может не произойти, клетка видоизменяется, приобретает иные качества.
Превышение нормы содержания в крови лимфоцитов, а также образование атипичных клеток может возникать при наличии рака. Наряду с ним существуют другие причины. Самая частая – инфекции, а также аллергия, от которой страдают жители мегаполисов. Приумножение числа лимфоцитов ведёт к лимфоцитозу.
Выявление клеток с нетипичными свойствами ассоциируется с опасными болезнями. Известны четыре основных группы факторов, влияющих на их возникновение:
- Присутствие в организме инфекций, вызванных вирусами, бактериями.
- Последствия интоксикации.
- Радиационное воздействие.
- Онкологические заболевания, наличие генетических патологий.
Нетипичные лимфоцитарные клетки образуются, если человек болен:
- Бруцеллёзом – заболеванием домашних животных, передающимся людям. Недуг протекает с поражением нервной системы, сердца, сосудов, костей, суставов.
- Лимфолейкозом – онкологией, при которой злокачественные клетки поражают ткани лимфы.
- Сифилисом – венерическим заболеванием с поражением кожных, слизистых покровов. Болезнь ухудшает состояние костной ткани, осложняет работу органов и систем.
- Токсоплазмозом – бессимптомной инфекцией, вызванной токсоплазмами. Источником заражения становятся кошки.
Лекарства и сыворотки, имеющие животное происхождение, также способствуют формированию реактивных лимфоцитов. У ребёнка этот процесс вызывают менингококковая инфекция, коклюш, корь, ряд других заболеваний.
Диагностика выявляет присутствие атипичных лимфоцитов у здоровых людей. Даже если взрослый человек не жалуется на проявления болезней, ему рекомендуют обратиться за консультацией к гематологу.
Реактивные лимфоциты в детском возрасте
Обозначение нормы состава крови детей и взрослых отличается. В организме здорового ребёнка отсутствуют атипичные лимфоциты. Часто причиной их появления становится мононуклеоз. При этой болезни нарушается целостность лейкоцитов, меняется состав их ядра. В результате иммунитет ослабевает, ребёнок заражается инфекциями.
Причинами лимфоцитоза у детей считают:
- вирусный гепатит;
- приём лекарств, таких как Тетрациклин;
- дефицит витаминов и минералов;
- проблемы пищеварительных органов;
- ветрянку, корь, скарлатину.
Ускорить выздоровление, избежать осложнений помогает ранняя диагностика. Выявить наличие проблемы способен анализ крови. Известный педиатр Комаровский рекомендует проводить такое исследование минимум один раз в год. Это позволит иметь сравнительные данные о составе крови, когда ребёнок здоров, а также во время болезни.
Симптомы
Атипичные лимфоциты никак не проявляются. Симптоматика возникает, когда болезнь поражает органы. Родители отмечают у детей:
- повышение температуры;
- появление сонливости, слабости;
- распространение инфекции на органы дыхания.
В ряде случаев появляются высыпания, кожа начинает зудеть. Отсутствие лечения ухудшает состояние. Требуется получить медицинскую помощь.
Лечение
Для нормализации состояния врачи проводят комплексную терапию:
- Лимфоцитарными препаратами снижают уровень лимфоцитов.
- Противовирусными, противовоспалительными средствами, антибиотиками борются с вирусами, инфекциями.
- Подбирают диету. Рекомендуют питание с высоким содержанием витаминов, микроэлементов. Ограничивают потребление жиров, соли.
- С онкологическими заболеваниями борются проведением курса химиотерапии.
Допустимые значения
Присутствие атипичных лимфоцитов допустимо у совершенно здорового человека, их норма – менее 6%. Повышенные показатели говорят о развитии патологии, необходимости начать лечение. В такой ситуации врач проводит диагностику и обследование. Для выбора лечения выясняют первопричину недуга.
Часто рекомендуют употреблять витамины, минералы, чтобы укрепить иммунитет. Заболевание вирусного характера лечат противовирусными препаратами. Аллергию устраняют противогистаминными, антиаллергенными средствами. Врачи советуют придерживаться диеты, исключить вредные привычки.
Клетки с атипичными свойствами в организме сигнализируют о проникновении вируса, развитии патологии. Обращение в поликлинику поможет выявить причину и устранить её.
Источник: https://onko.guru/termin/atipichnye-limfotsity.html
Появление атипичных лимфоцитов в анализе крови. могут ли при аллергии быть повышены лимфоциты
Лимфоцитами называют разновидности клеток крови, отвечающих за защитные процессы организма при его поражении различными заболеваниями.
Атипичные лимфоциты являются модификацией «стандартных» белых кровяных телец, отличающихся размерами и «рабочими» свойствами.
В идеале у здорового взрослого человека или ребенка количество лимфоцитов в крови должно попадать в границы пределов референтной нормы.
Количество телец значительно возрастает тогда, когда организм пациента приступает к борьбе с какой-либо проблемой, поражающей ткани, органы или иммунную систему.
Состояние, при котором лимфоциты повышены, называют лимфоцитозом. Иногда патология может наблюдаться и у внешне здоровых людей, не имеющих жалоб на какие-либо проблемы с самочувствием.
В таком случае при выявленном и подтвержденном повторными анализами лимфоцитозе пациентам следует посетить профильного врача – гематолога, занимающегося исследованием патологий крови.
Атипичные лимфоциты бывают различных видов. Данные виды названы в честь врачей, исследовавших болезни крови и впервые обнаруживших тот или иной вид атипичных клеток.
Первая группа атипичных телец называется клетками Дауни. Впервые они были выявлены в первой трети двадцатого века у пациентов, страдающих от патологий, спровоцированных наличием цитомегаловируса или вируса Эпштейна-Барра.
Вторая группа атипичных лимфоцитов названа в честь известного гематолога Ридера, исследовавшего различные патологии крови своих пациентов.
Ридер выявил, что у многих из тех, кто страдали от острой лейкемии, лимфоциты приобретают иное строение.
В частности, ядра таких лимфоцитов словно разделены пополам и обладают неравным контуром. Иногда тельца данной группы называют амитотическими.
READ Отличия норм биохимического анализа крови у беременных
Третья группа атипичных лимфоцитов называется клетками Боткина-Клейна-Гумпрехта. Основное заболевание, провоцирующее появление данных атипичных телец, – лимфаденоз.
Клетки данного вида не обладают какими-либо полезными функциями, но при этом постоянно находятся в крови пациентов, страдающих от патологий. В некоторых медицинских источниках можно встретить альтернативное название данных атипичных лимфоцитов, звучащее как «тени Боткина-Клейна-Гумпрехта».
Разновидности атипичных лимфоцитов
Атипичные лимфоциты появляются в организме под воздействием различных антигенов. Главной отличительной чертой является увеличенный размер клеток.
Для сравнения, размер «стандартных» телец колеблется в районе десяти – двенадцати микрометров, размер атипичных лимфоцитов составляет около тридцати микрометров.
Стандартные лимфоциты имеют характерную круглую форму, а лимфоциты, обладающие атипичным происхождением, могут видоизменяться, превращаясь в многоугольные клетки, обладающие неравномерными по длине рваными гранями.
Главные изменения, специфические для атипичных лимфоцитов, происходят внутри их ядер.
В ходе лабораторного исследования данных клеток можно обнаружить, что внутри них располагаются не обычные, гладкие и слегка удлиненные ядра, а ядра вытянутой формы, покрытые микротрещинами и небольшими вмятинами.
Анализ крови, направленный на выявление атипичных телец, предполагает использование специализированных реактивов, позволяющих правильно оценить окрас клеток.
В качестве дополнительных реактивов традиционно используются вещества, называемые «гематоксилином» и «эозином».
После взаимодействия с данными веществами лимфоциты атипичного вида, находящиеся в составе биологического материала пациента, взятого на анализ, приобретают темно-серый или синеватый цвет, причем их ядра окрашиваются в оттенки фиолетового цвета. Классические лимфоциты имеют жемчужный, слегка сероватый или желтоватый оттенок.
Повышенное количество лимфоцитов в крови пациента может быть спровоцировано различными факторами. Выделяют реактивный, постинфекционный и злокачественный лимфоцитоз.
Реактивный лимфоцитоз появляется вследствие значительно ослабленного иммунитета.
Организм, незащищенный даже от не самых значительных патологических ситуаций, порождает большое количество как обычных, так и атипичных телец, обладающих большими размерами и неспособных эффективно бороться с заявленными проблемами.
Постинфекционный лимфоцитоз является наиболее безопасным для человека, так как носит временный характер.
Основной причиной его появления называют вирусные или инфекционные заболевания, перенесенные в недавнем прошлом.
READ Названия и виды анализов крови
Злокачественный лимфоцитоз – патологический симптом, характерный для людей, страдающих от каких-либо онкологических заболеваний.
Онкология стимулирует организм человека вырабатывать огромное количество лимфоцитов, часть из которых перерождается в атипичные клетки.
Причины появления
Если анализ крови покажет присутствие в биологическом материале атипичных лимфоцитов, то не стоит паниковать и думать о плохом.
В подавляющем большинстве случаев их нахождение будет оправдано недавно перенесенными вирусными заболеваниями или различными аллергическими процессами, протекающими в тканях организма.
Чтобы нивелировать проблему и не спровоцировать развитие более серьезных патологических ситуаций, следует заняться восстановлением иммунной системы.
:
После ее восстановления иммунитет перестанет производить на свет неполноценные, атипичные кровяные тельца и вновь будет готов к борьбе с возможными заболеваниями.
Однако в некоторых случаях наличие атипичных телец в крови у ребенка или взрослого может указывать на ряд достаточно серьезных патологий, которые требуют либо незамедлительного (и зачастую радикального) лечения либо тщательного контроля врача над их течением.
Речь идет о таких патологиях, как:
- лимфолейкоз (поражение лимфатической системы раковыми клетками);
- бруцеллез (заболевание инфекционного спектра, передающееся людям от контакта с животными и негативным образом сказывающееся на правильной работе нервной и сердечно-сосудистой систем);
- сифилис (инфекция, поражающая слизистые ткани, костную и нервную систему);
- токсоплазмоз (заболевание, не имеющее ярко выраженных симптомов, но при этом в острой форме разрушающее все системы организма);
- пневмония, ветрянка, гепатит и проч.
Кроме того, появление атипичных лимфоцитов в организме человека может быть вызвано длительным лечением каких-либо патологий, в ходе которого использовались специализированные сыворотки животного происхождения, предназначенные для повышения радикально ослабленного иммунитета.
Данные сыворотки могут восприниматься телом пациента, получающего лечение, в качестве инородных реагентов, поэтому его организм может начать бороться с компонентами, входящими в их состав, используя остатки собственной, но изрядно истощенной иммунной системы.
READ Основные функции лимфоцитов в крови
В чём проявляется атипичность лимфоцитов?
Как известно, лимфоциты участвуют в процессах иммунного ответа — то есть, одни из первых бросаются на борьбу с опасными микроорганизмами. В результате этой борьбы они могут приобретать следующие параметры:
- Нестандартный внешний вид
Обычно лимфоцит имеет круглую форму и ровные границы. Атипичные лимфоциты отличаются рваными контурами и неправильной многоугольной структурой.
В нормальном состоянии размер лимфоцита не превышает 12 мкм. Увеличение этого показателя говорит о его атипичности.
Воздействие патогенных организмов распространяется также и на ядро клетки — если посмотреть на неправильный агранулоцит через микроскоп, можно обнаружить, что оно вытянуто, удлинено, испещрено продолговатыми трещинками.
Атипичные лимфоциты также имеют более яркий окрас, при добавлении в анализируемую кровь красителя гематоксилина — это также один из способов выявления необычных клеток.
А вы знали, что черты характера человека влияют на его уровень сопротивляемости болезням? Есть исследование, подтверждающее, что активные и уверенные в себе люди вырабатывают большее количество клеток иммунного ответа, что и помогает им бороться с болезнями. Таким образом, оптимистичный и положительно настроенный человек имеет меньше поводов для беспокойства о своём здоровье.
Где находятся атипичные лимфоциты:
Обнаруживают их главным образом в крови, так как именно кровь берут на анализ, чтобы изучить эритроциты, лейкоциты, лимфоциты и прочие важные показатели. Но в тканях их тоже немало.
В организме взрослого человека может быть 6% атипичных лимфоцитов, даже если этот человек полностью здоров.
Когда же в связи с болезнью у пациента наблюдаются высокие лимфоциты в крови, то показатель атипичных может подниматься до 7-10% и выше.
Каким анализом определяется
Для определения количества иммунных клеток нужно сдать общий анализ крови. Важно подготовиться предварительно к сдаче биологической жидкости, чтобы получить более точные результаты.
За сутки необходимо отказаться от интенсивных физических нагрузок, употребления жирной пищи. За 2-3 часа до процедуры нужно воздерживаться от курения. Кровь сдают натощак.
В большей части случаев берут из пальца, из вены — реже.
Источник: https://GolovaNeBoli.ru/sosudy/atipichnye-limfotsity-v-analize-krovi-chto-eto-takoe-i-pochemu-poyavlyayutsya.html








